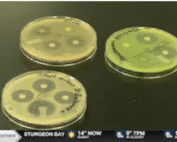
petri dishes featuring zones of inhibition

The Latest
Researchers at UW–Madison Receive Major Grant to Study the Link Between Mental Health and the Microbiome
Long before science caught up, Vincent Van Gogh sensed a connection between melancholy and microbes. Now, 135 years later, the Wisconsin Institute for Discovery, the Center for Healthy Minds, PRECISE, and MIT have launched a project that investigates the microbiome’s central role in human well-being and the power of interdisciplinary research. Combining genomics, data science, behavioral health, and international collaboration, the research project is advancing a global understanding of how microbes shape the mind.
How disabling one gene protects mice against Type 1 diabetes
In collaboration with the Feyza Lab, Khagani Eynullazada, a grad student from Sushmita Roy’s lab identified gene regulatory networks capturing shared and perturbation-specific stress pathways in Type 1 diabetes using GRN inference tools on scRNA-seq data from in vivo mouse models.
Tiny Earth Combating Antibiotic Resistance Featured on NBC15 Madison
Students at Northeast Wisconsin Technical Collage (NWTC) are looking for ways to fight antibiotic resistant bacteria as part of an eight-year project with Tiny Earth, a worldwide initiative headquartered at the Wisconsin Institute for Discovery.
Ulugbek Kamilov uses machine learning to make biomedical and scientific imaging faster and more adaptable
Kamilov, recently invited to join the ranks of Discovery Fellows at WID will share his expertise developing AI and mathematical methods for computational imaging. We look forward to his future collaborations.